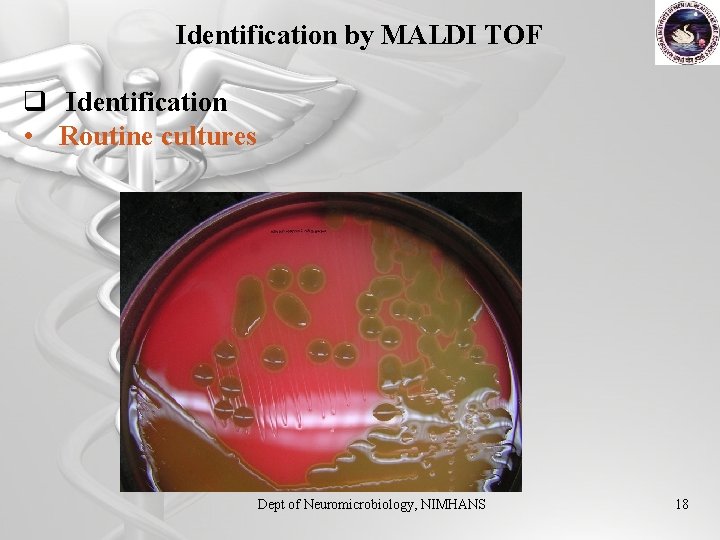
Identification by MALDI TOF q Identification • Routine cultures Dept of Neuromicrobiology, NIMHANS 18

MALDI TOF analysis of Streptococcus pneumoniae from Cerebrospinal

MALDI TOF analysis of Streptococcus pneumoniae from Cerebrospinal Fluid for the diagnosis of Acute Bacterial Meningitis Dr. R. Ravikumar, M. D. , Professor of Neuromicrobiology Dept. of Neuromicrobiology National Institute of Mental Health & Neuro Sciences Institute of National Importance Bangalore, Karnataka. ravikumarbly@yahoo. co. uk 1

INTRODUCTION Streptococcus pneumoniae Staphylococcus aureus Acute Bacterial Meningitis Other Streptococci Haemophilus influenzae Neisseria meningitidis 2

Ø As of March 2012, the World Health Organization estimates that globally 476, 000 (333, 000 – 529, 000) HIV negative child deaths under five years of age occurred during 2008 due to pneumococcal (Streptococcus pneumoniae) infections Ø Some reports have suggested that this bacterium causes: • More than 50% of cases of community-acquired pneumonia admitted to hospitals • About 20– 40% of all pyogenic meningitis. 3

Ø In India, Pneumonia is the single most important cause of death among children in the post neonatal period, contributing as much as 27. 5% of total under-five mortality Ø In 1999, as per a prospective multicentre surveillance study by the IBIS group, the meningitis associated with pneumococcal infection had a case fatality rate of 34%. 4

Ø In India, an 8 year study (Khan 2011) showed that 8. 2% of the bacterial meningitis cases were caused by Streptococcus pneumoniae. Ø According to the Pneumo. NET study conducted in Bangalore certain serotypes such as 6 A and 19 A are most prevalent. Globally 19 A represents 5% of all cases. 5

Ø In a study done in USA , it was observed that pneumococcal isolates from 9% of the cases were resistant to cefotaxime, and isolates from 11% had intermediate susceptibility. 6

1996 - 2005 (10 years) Ø 385 patients with community acquired acute bacterial meningitis were diagnosed and treated at NIMHANS. 13. 2 23. 9 76. 1 86. 8 7

70 60 50 40 S pneumoniae H influenzae N meningitidis 30 20 Number 238 7 4 Isolate % 61. 8 1 10 0 S pneumoniae H influenzae N meningitidis Other gram negative bacilli, Streptococcus spp. and Staphylococcus aureus were isolated from 19 (4. 9%), 9 (2. 3%) and 7 (1. 8%) cases respectively Mani etal; IJMM 2007; 25: 108 -14 8

Diagnosis of S. pneumoniae Microscopy based • • Culture Methods CSF Microscopy CSF cell count & Typing Gram’s staining CSF cytospin –Leishman’s staining • Blood Agar • Chocolate Agar • Vitek 2 C 60 system Immunological investigations • Latex agglutination tests Molecular Technique • PCR- Gene coding for pneumolysin 9

Microscopy based diagnosis CSF cytospin –Leishman’s staining 10

Microscopy based diagnosis Gram’s Staining India Ink Staining 11

Gram’s stained CSF smear 12

CSF smear : Cytospin Preparation 13

CSF Culture: Conventional & Automated Growth in chocolate agar Growth in Sheep blood agar 14

Vitek Ø Automated system for microbial identification and antibiotic sensitivity testing Ø Biochemical basis of identification Ø Minimum Inhibitory Concentration is the basis of AST 15

VITEK 2 C 60 AUTOMATED CULTURE MACHINE

Antigen Detection of soluble antigens of S. pneumoniae in CSF is performed by latex agglutination tests (LAT), using commercial kits PCR The gene coding for pneumolysin, a 52 k. Da pneumococcal toxin protein, is chosen as a target for amplification. 17
Identification by MALDI TOF q Identification • Routine cultures Dept of Neuromicrobiology, NIMHANS 18

19 Fournier et al. Nature Reviews Microbiology 11, 574– 585 (2013)

Dept of Neuromicrobiology, NIMHANS 20






Streptococcus pneumoniae typing • S Pneumoniae poses antigenic capsule with more than 80 different subtypes. • Serotyping is done using Latex agglutination, Quelling reavtion or Sequencing. • The World Health Organization has recommended latex agglutination or Quelling reaction as a test for serotyping pneumococci. • Serotyping pneumococcal isolates is important for assessing the impact of vaccination programs and for epidemiological purposes. 26

27

Latex agglutination 28

Results Ø From the CSF samples received for acute meningitis workup for one year, 13 cultures were positive for Streptococcus pneumoniae. Ø The identification was confirmed by conventional and automated method by Vitek 2 C and Mass Spectrometry. Ø MALDI TOF mass spectrometry scores for Streptococcus pneumoniae obtained were more than 1. 900 (1. 926 to 2. 345) indicating good identification confidence. 29

Ø Serotyping showed that 4 of 13 strains belonged to type 1 and two type 9 strains. Ø Other strains belong to type 22 F, 33, 6 B, 15 B, 7 F, 19 and one non typeable strain was identified. Ø Of the 13 strains tested for drug susceptibility, 7 were sensitive strains, 3 strains were resistant to cotrimoxazole and 2 strains to erythromycin, one strain was resistant to cotrimoxazole, erythromycin, penicillin and clindamycin. 30

Serotyping of S. pneumoniae 31

lid zo co m V an n pr yc Te im tra in /S ul cy fa cl m in et e ho xa Co zo tri le m ox az ol e ho im et Tr Li ne n yc i n ci yc i m in da Cl ro m th Er y e xo ne lo xa vo f Le ia ftr Ce in ill ax im ot Ce f ni c Pe % sensitivity Antibiotic sensitivity 120. 00 100. 00 80. 00 60. 00 40. 00 20. 00 Antibiotics 32

w Penicillin resistance was low at 7. 7% overall. w Resistance to co-trimoxazole was noted to be high 46. 2% in 1993 to 85. 2% in 2008 w Streptococcus pneumoniae is naturally highly susceptible to penicillin G, which has been the main therapeutic agent over the past 40 years. However, penicillin-resistant pneumococci (PRP) are becoming more prevalent world 33

Acknowledgements • Dr. Keshav Prasad, Faculty Scientist, Institute of Bioinformatics, Bangalore. • All faculties, students and other staff, Dept. of Neuromicrobiology, NIMHANS, Bangalore. • Centre of Excellence, Bruker Daltonics, Bangalore. • bio. Merieux, India. Dept of Neuromicrobiology, NIMHANS 34


36
- Slides: 36